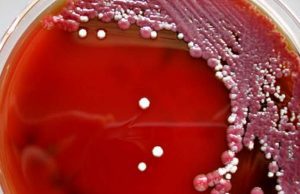
Il batterio sul sapone ospedaliero contaminato

Consumatori Italia
La Russia sospende i visti turistici per gli italiani
Mosca prende la decisione di sospendere il rilascio dei visti ai cittadini italiani
Nello specifico il Centro operativo per contrastare la diffusione del Coronavirus russo...
Coronavirus | Sospesi i traghetti tra Tunisia ed Italia
Le merci posso viaggiare. I soli cittadini tunisini possono partire da Marsiglia
Anche la Tunisia ha bloccato il collegamento con l’Italia via mare. Tutti i...
Ryanair cancella i voli da e per l’Italia: i rimborsi dei...
Ryanair, martedì 10 marzo, in seguito alla decisione del governo italiano mettere in ‘zona rossa’ tutta l’Italia al fine di contenere la diffusione del...
Autocertificazione Coronavirus | Ecco il modulo del ministero da scaricare
A causa delle restrizioni in vigore su tutto il territorio nazionale, il ministero dell’Interno ha predisposto un modulo necessario per giustificare il movimento nelle...
Spostamenti della popolazione permessi per salute o lavoro
Esteso il provvedimento varato nella notte tra sabato e domenica a tutte le regioni
Ulteriore giro di vite provocato dalla grave accelerazione nel Paese del...
Il batterio sul sapone ospedaliero contaminato
La Serratia, ha ucciso una neonata in ospedale. In Spagna tre anni fa 51 neonati colpiti in un reparto
"Serratia marcescens" è il batterio della...
Coronavirus | Stop ad udienze civili e penali per due settimane
L’astensione è stata indetta dall’ Organismo Congressuale Forense
Organismo Congressuale Forense ha indetto l'astensione dalle udienze e da tutte le attività giudiziarie da domani 6...
Coronavirus | Garante Privacy su obblighi lavoratori e datori di lavoro
La diffusione del Coronavirus pone diverse questioni anche in termini di privacy e tutela della stessa.
Come si devono comportare i datori di lavoro? Devono...
Guida senza patente dei fuoribordo a due tempi fino a 40...
È stata pubblicata in Gazzetta ufficiale la Legge 28 febbraio 2020, n.8, entrata in vigore il 1° marzo, che comprende una disposizione che garantisce...
Coronavirus, cosa c’è da sapere e come scegliere la mascherina giusta
L'attuale Coronavirus, il cui nome ufficiale è SARS-CoV-2, è un ceppo virale che sta gettando il panico presso le popolazioni di diverse aree del...